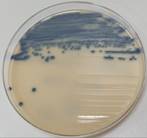
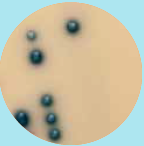

Fagbioingeniør, faggruppe II har ansvar for vedlikehold av denne prosedyren. Alle som er opplært i VRE-screening har ansvar for å følge denne prosedyren.
Benytt hansker og smittefrakk ved utsåing av prøver. Såes ut i LAF-benk. Skålene kan vurderes på benk.
Med. mikrobiologi er med i SLP/ringtestprogrammet til Folkehelseinstituttet.
Kontrollstammer som benyttes:
Tabell 1.0
|
Kontrollstammer: |
Egenskap: |
|
Enterococcus faecalis (ENFÆ) ATCC 29212 |
Negativ |
|
Enterococcus faecalis VanB (ENFÆ) ATCC 51299 |
Positiv |
Figur 1.0; Bildene viser skål med etiketter og oppvekst av positiv kontroll.

Ved screening for VRE-bærerskap anbefales alltid penselprøve fra rektum,
men alle materialer som er rekvirert for VRE-screening
kan benyttes (unntatt UTM med rød topp, for virus us).
NB: Merk at ESBL screening skal gjøres rutinemessig på alle VRE fra rektum dersom det ikke opprinnelig er bestilt fra rekvirent.
Innregistrering: Prøver skal registreres som VRE.
Søkeord i prosedyrefelt: VRE, velg prosedyre:
X-Vankomycinresistente enterokokker (VRE) dyrkning LAB1233030142000.

Dersom det kun er mottatt prøver fra andre lokalisasjoner enn rektum skal følgende kommentar være med:
|
FVR1: |
Ved screening for VRE–bærerskap anbefales alltid penselprøve tatt fra rektum. |
Prøvemateriale tatt på Copan e-Swab (transportmedium) kan oppbevares og analyseres innen 48 timer (gjelder for rom.temp og 4-8°C).
Skålene oppbevares på kjølerommet i originalemballasjen
(kjølerom K1).
Skålene må oppbevares mørkt og kjølig i originalemballasjen.
Oxoid Brilliance™ VRE Agar, heretter kalt VRE-agar,
romtempereres før bruk. Når prøvene romtempereres MÅ de oppbevares mørkt, dekk
til skålene med trekk. Sørg for at skålene er tørre før de tas i bruk.
NB: skålene kan IKKE tørkes/tempereres
i inkubator før bruk.
BD CHROMagar Orientation Medium/Columbia CNA Agar (heretter kalt; delt-agar) benyttes for adekvat tatt prøve.
v Kontaminerte skåler.
v Holdbarhetsdato er overskredet.
v Må ikke benyttes dersom det er fargeomslag i agar.
v Oppbevaring av skåler ved feil temperatur (frost/overoppheting).
v Lyseksponering, kan hemme kromegenskaper i mediet.
v Må stå aerobt uten syre (C02) syre kan forskyve pH balansen og dermed forringe krom egenskaper.
v Kjøres ikke på WASP.
v Se for øvrig pakningsvedlegg under relatert.
Prøven såes ut i LAF-benk. Benytt hansker og smittefrakk.
Utsåing av pasientprøver:
NB: 1 pasientprøve pr agar.
|
1. |
Vortex prøvemateriale i ca 5 sekunder. |
|
2. |
Benytt sterilpipette, drypp 1 dråpe på VRE-agar og delt-agar, så deretter ut med blå-øse i 3 kvadranter på VRE-agar, delt-agar som vanlig. |
Utsåing av kontrollstammer:
v Kontrollstammer skal være med ved hvert oppsett (1 pr dag).
v Kontrollstammer tilsettes i copan E-swab husk å merke rør med kontrolletiketter og tilsatt dato.
v Kontrolletiketter ligger på prøveplass.
v Kontrollene kan benyttes i en uke etter at de er tilsatt i copan E-swab
v Kontroll-agar merkes med etiketter for VRE kontroll. Benytt 1agar. Se figur 1.0
|
1. |
Vortex prøvemateriale i min 5 sek. |
|
2. |
Benytt sterilpipette, drypp 1 dråpe på VRE-agar, så deretter ut med blå øse. |
Prøver samt kontroller dekkes til med klede og inkuberes aerobt
(Inkubator I10 salmonella/shigella inkubator, vanlig atmosfære) i 18-28 timer (ideelt 20-22 timer).
Skålene skal stå i 2 døgn. Dvs. at negative prøver kan besvares etter 48 timer.
Vekstkontroll av kontrollstammer skal føres i skjema for
vekstkontroller.
Skjema tigger på Teams, mappe kontroller, skal føres i dokument:
registrering for daglige og ukentlige kontroller; i fanen for ESBL og VRE
kontroll.
Fæces eller blodig materiale kan føre til fargeomslag i selve agaren. Dette skal ikke vurderes som vekst da positiv oppvekst vokser med tydelig kolonier.
Tabell 1.1 viser: Differensiering og/eller identifikasjon av isolatene på grunnlag av kolonienes farge og utseende.
|
krom-egenskap |
Ved vekst på VRE-agar |
|
Lys rosa/lilla farge: |
E. faecium |
|
Blå/grønn farge: |
E. faecalis |
|
E. cassiluflavus og E. galirnarium innhiberes stor sett på dette mediet. |
|
Figur 1.1; Eksempler av forventet vekst på agar:
E. faecium, rosa/lilla kolonier E. faecalis
blå/grønne kolonier.
Ved ingen vekst SKAL skålene inkuberes i nye 24 timer.
De kromogene egenskapene til skåla skal bare benyttes til foreløpig identifikasjon av mikroben. All oppvekst skal identifiseres med MaldiTof ALM-MM-Bakt; MaldiTof Sirius, bruk og vedlikehold
Andre gram positive/negative bakterier skal stort sett inhiberes. Det samme gjelder for gjærsopp.
Ved funn av enterokokker på VRE-agar settes det opp følsomhetsbestemmelse.
Relevant oppvekst spres på blodagar før resistensbestemmelse. Følsomhetsbestemmelse skal ikke utføres direkte fra VRE-agar da antibiotika i mediet kan påvirke resultatet.
Spredninger gjort tidlig på dagen som umiddelbart settes i inkubator kan gi nok materiale til følsomhetsbestemmelse på slutten av dagen. Spredninger kan settes i inkubator I9 (Co2 inkubator).
Tabell 1.2
|
Alle nye funn av enterokokker. Gjelder for E. faecalis og E gallinarium. |
|
|
Antibiotika |
Diskdiffusjon |
|
Ampicillin 2µg |
|
|
Gentamicin 30µg |
|
|
Imipenem 10µg |
|
|
Linezolid 10µg |
|
|
vancomycin 5µg. |
|
For tolkning: se NordicAST.org benytt siste oppdaterte versjon.
v E.faecalis og E.faecium:
Sendes K-res. For rekvisisjon; se under relatert.
v Andre enterokokker som f.eks: E.casseliflavus og E.gallinarum: er iboende resistente mot vankomycin synes ikke å ha et epidemisk potensiale. Disse har vanC.
v Alle nye funn skal fryses i boks 5.
v VRE er nominativt meldepliktig.
v Linezolidresistente enterokokker (LRE) er nominativt meldepliktig.
Se også: ALM-MM-Bakt; Varsling, frysing og videresending av bakterieisolat.
Nytt funn:
Anses som nytt funn dersom det har gått mer enn 12 måneder mellom funn.
Utbrudd:
Def. av mistenkt utbrudd fra FHI:
To eller flere tilfeller av samme sykdom som mistenkes å ha
felles kilde, eller
et antall tilfeller som klart overskrider det man ville forvente (det endemiske
nivået - det normale bakgrunnsnivået av sykdommen) innenfor et område i et gitt
tidsrom.
Kilde: Definisjon av utbrudd FHI
For VRE og LRE:
Konfirmasjonstest utføres en gang pr. kalenderår, hvis artsidentifikasjon er lik
Det er dermed ikke nødvendig med ny følsomhetsbestemmelse, kun identifisering på Maldi-tof.
Negative prøver skal besvares etter 48 timer.
Alle funn skal ha med smittekommentarer.
For smittekommentarer melde/varsle
se; ALM-MM-Bakt; Varsling, frysing og videresending av bakterieisolat.
Ved påvist VRE SKAL mikrobiolog varsles FØR prøven besvares (gjelder nye funn).
Alle funn skal varsles telefonisk til rekvirent.
Dette skal registreres i kom.logg. Skal gjøres via oppfølgingsoppgaveliste.
NB: Husk å hake av for meldepliktig MSIS flagg i Beaker.
Tabell 1.3
|
Besvarelse av VRE |
|
|
Funn |
Besvarelse |
|
IV |
NEG |
|
VRE Nytt funn |
Mikrobenavn Vancomycin resistent enterokokk påvist. .SMITTE .MERK .NMSY |
|
VRE Tidligere påvist |
Mikrobenavn Vancomycin resistent enterokokk påvist. .VREK .MERK .SMITTE |
|
Besvarelse av LRE |
|
|
Negativ |
Besvares ikke til rekvirent. Skal kun ut til rekvirent ved positivt funn. |
|
LRE Nytt funn |
V Mikrobenavn Linezolid resistent enterokokk påvist .SMITTE .MERK .NMSY |
|
LRE Tidligere påvist |
V Mikrobenavn Linezolid resistent enterokokk påvist Tidligere påvist. .MERK .SMITTE |
Dersom ingen vekst på delt-agar (gjelder ikke ved påvist VRE/LRE)
ta da med kommentarene; NB: unntak her er opplysninger om immunsupprimert
.KPIT
.NYPA
Dersom stammen er både VRE og LRE, besvares prøven som nytt under VRE og nytt LRE-funn.
For LRE se: ALM-MM-Fæces; Påvisning av linezolid resistente enterokokker
Følsomhetsbestemmelse skal ikke ut i svarrapport.
Tabell 1.4
|
Kriterier for sending |
Gjeldende isolater |
Sendes til |
DD skal påføres rekvisisjon |
Sendes på Copan Eswab m/hvit kork |
|
Påvist VRE
|
E. faecalis/E. faecium |
K-res |
JA |
|
|
Påvist LRE |
Enterococcus spp |
Stammer som sendes K-res (ref.lab):
Ved sending til ref.lab:
1. Velg rekvisisjonsoppføring.
2. Legg til i prosedyrefelt: Mikrobiologi, referanselab, sendeprøve
(tips: søk i prosedyrefeltet med XS, trykk deretter enter)
3. Hak av for riktig ref. lab her; UNN.
4. Legg også til prosedyren Mikrobiologi, referanse lab, sendeprøve, svar (søkeord: XS).
5. Åpne pakkelisteredigering og scann inn prøven. Pakk og sendes til ref. lab.
6. Besvares som sendt.
7. K-res skal ha med utfylt rekvisisjon, ligger under relatert. Før sending: Husk å scanne rekvisisjon inn i BEAKER.
Prøver til K-res skal sendes med post. Husk å merke konvolutt med klistremerke for biologisk materiale.
Når svar fra K-res foreligger:
Tabell 1.5
|
Kriterier ved besvarelse fra K-res: |
Ut i svarrapport: |
|
Id bekreftet av referanselaboratoriet |
.FBRE |
|
Samsvar av følsomhetsbestemmelse |
.REL |
|
Avvik av følsomhetsbestemmelse |
.RER |
NB: Dersom negativ PCR skal svar resultat korrigeres. Rekvirent skal da kontaktes. Dette skal registreres i kom logg.
Ved slike tilfeller konferer med medisinsk faglig rådgiver. Eller fagbioingeniør og spesialbioingeniør.
For besvarelse se også EQSID: ALM-MM-Admin; Svarrapportering ved Lab. for medisinsk mikrobiologi
Tabell 1.6 viser: Forklaring av kortkoder:
|
KORTKODER: |
FORKLARENDE TEKST: |
|
.SMITTE |
Se helseinstitusjonens smittevernprosedyrer og/eller Folkehelseinstituttets Smittevernhåndbok (https://www.fhi.no/sm/smittevernhandboka/). |
|
.FBRE |
Funnet bekreftet av referanselaboratoriet. |
|
.REL |
Referanselaboratoriets resistenstesting samsvarer med tidligere besvart resistensoppsett. |
|
.RER |
Referanselaboratoriets følsomhetstest samsvarer ikke med tidligere besvart følsomhetstest. Referanselaboratoriets svar bør vektlegges tyngst. |
|
.VREK |
Tidligere kjent positiv VRE |
|
.KPIT |
Ingen vekst av tarmflora. Korrekt prøvetaking? |
|
.NYPA |
Ny prøve anbefales. |
|
.MERK |
Husk å merke i journal, under kritisk info., om res.mekanisme |
|
.NMSY |
MSIS-M: MSIS-melding - klinikermelding skal sendes Hvis ikke klinikermelding er sendt tidligere, skal rekvirerende lege sende elektronisk klinikermelding (https://klinikermelding.fhi.no) eller utfylt meldingsskjema (https://www.fhi.no/msis) per post. |